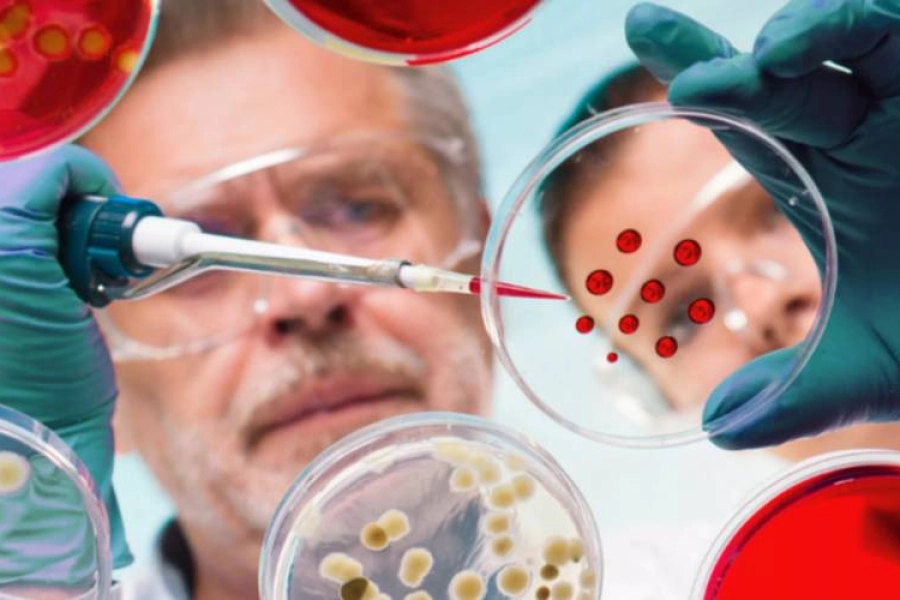
Цой рассказал, какой штамм коронавируса опасней для казахстанцев

Сегодня в Казахстане выявлена циркуляция «британского» и «южно-африканского» штаммов
По данным Всемирной организации здравоохранения «британский штамм» выявлен в 130 странах мира, «южно-африканский» в 80, «бразильский» - 45 странах. Такие данные привел министр здравоохранения РК Алексей Цой, передает корреспондент Bestnews.kz.
По данным министра, в марте на территории республики выявлена циркуляция «британского» и «южно-африканского» штаммов.
«Недавние исследования показывают, что британский вариант коронавируса связан с более высокой вероятностью госпитализации и смерти, чем исходный штамм. Бразильский штамм не считается более смертоносным, но он распространяется легче, чем исходный штамм COVID-19. Также установлено, что британский штамм коронавируса распространяется быстрее, по сравнению со штаммом прошлого года в 1,7 раза, южноафриканский в 1,5 раза и бразильский - в 2 раза», - подчеркнул Цой сегодня, 6 апреля на заседании Правительства РК.
При этом «рост репродуктивного числа может увеличиться с 1,1 до 1,9 что постепенно приведет к доминированию этих штаммов.»
«Заболеваемость растёт»: Цой призвал акимов подготовить инфекционные койки и бригады «скорой помощи»
«Принятые Правительством ограничительные меры с 2020 года, позволили в течении 6 месяцев не допустить завоз новых вирусов. Мониторинг новых штаммов продолжается», - сказал Алексей Цой.
Иллюстрация: interaztv.com
Читайте новости по меткам:
горячие новости 59 Авиакатастрофа в Актау 46 Барыс 31 Город Астана 17 Президент Казахстана 14 футбол 14 хоккей 12 Алматы 12 происшествия 12 Новый год 11 авиация 11 погода 8 доллар 7 Талгар 6 МИД РК 6 Фото 5 бокс 5 убийство Шерзата Болата 5 Эксклюзив 5 ФК Астана 5 Россия 5 правительство 5 дети 5 новости министерств 5 регионы Казахстана 4 МВД 4 Серик Жумангарин 4 громкие дела 4 Сенат 4 армия 4